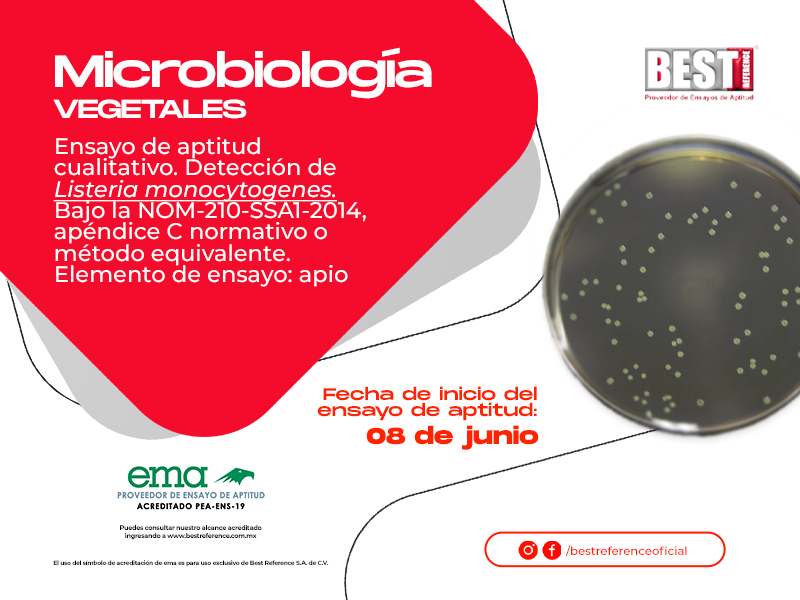

PRÓXIMOS ENSAYOS

MÉXICO
Algunos de nuestros clientes internacionales se encuentran en: Chile, Honduras, Paraguay, Guatemala, Ecuador, Colombia, El Salvador, República Dominicana, Perú y Uruguay.
NUESTROS SERVICIOS
Los ensayos de aptitud que ofrecemos son en las siguientes magnitudes para calibración:
Para laboratorios de ensayos:
COMPARACIÓN DE
INTERLABORATORIOS
Participa en nuestros programas de comparación interlaboratorio y fortalece la confianza en tus resultados
Best Reference México
Cuenta con profesionales, reconocidos por su gran experiencia para gestionar, organizar y evaluar los programas.
La norma que regula los ensayos de aptitud y con la cual cumple nuestra empresa Best Reference, es la ISO/IEC 17043:2023 "Evaluación de la conformidad - Requisitos generales para la competencia de los proveedores de ensayos de aptitud".
Acreditados ante ema
Consulta nuestro alcance aquí:
Alcance acreditado
OTROS SERVICIOS
MÉXICO
0
Ensayos
0
Clientes
CONTAMOS CON LA MEJOR TECNOLOGÍA
En BEST REFERENCE contamos con un sistema de ayuda que nos permitirá darte un seguimiento acompañado, personalizado durante tu ensayo de aptitud que te facilite obtener o mantener tu acreditación.
NUESTRAS ACREDITACIONES SON:
Una constante actualización para brindar a nuestros clientes la mejor experiencia
Inicio
Recepción de queja o apelación por cualquier medio de los siguientes: Correo electrónico, vía telefónica, carta u oficio, personalmente, opinión a través de la encuesta de satisfacción código BR-F-5.7-01.
El gestor de calidad se asegura que la queja o apelación contiene: Descripción detallada de la misma e identificación de la parte interesada.
Best Reference acusa de recibido en el proceso de apelación a más tardar en 3 días hábiles.
El responsable del SGC asigna número de ingreso y seguimiento a la queja o apelación, emitiendo un resultado a más tardar en 10 días hábiles.
El gestor de calidad somete a investigación la queja o apelación.
Los resultados de la investigación se hacen del conocimiento de la dirección de Best Reference quien autoriza las acciones correctivas que pudieran ser requeridas.
El gestor de calidad envía respuesta a la persona que interpuso la queja o apelación, mediante el formato de registro de quejas y apelaciones código BR-F5.8-01-01.
El interesado tendrá 30 días para indicar si está conforme o no, con la resolución enviada por parte de Best Reference.
No
¿Acepta resolución?
Si
Cierre de proceso de queja o apelación.
Fin
Organismo proveedor de ensayos de aptitud, respaldado por mexicanos profesionales en física, química e ingeniería.
Somos un equipo de profesionales con experiencia en calibración de instrumentos de magnitudes como óptica, masa, volumen, presión, temperatura, dimensional, humedad y simulación eléctrica.
¿Cómo podemos ayudarte?
¡El primer paso es ponerte en contacto! Te responderemos a la brevedad posible. Además, estamos abiertos a recibir tus solicitudes para nuevos proyectos y propuestas innovadoras. ¡Esperamos poder trabajar contigo!
Reportar queja o problema.